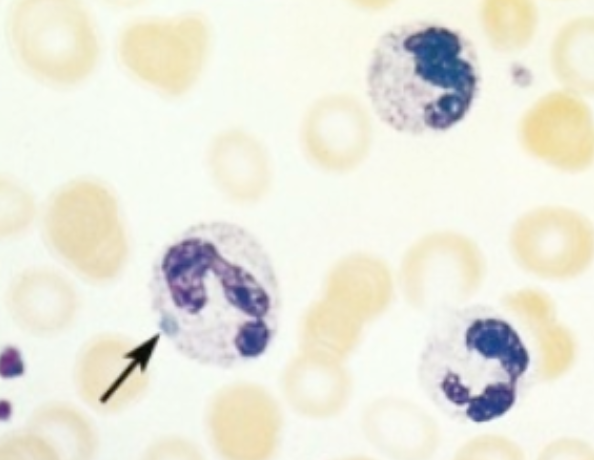

Complications of blood transfusions (2)
- Hepatitis A or B
- HIV

Bone marrow cellularity < ____ %, plts < _____/mm3, reticulocytes < ______/mm3 = very severe aplastic anemia
- 25
- 20,000
- 20,000
Advanced HIV tx (2)
- tx opportunistic infections
- HAART (20% causes anemia)
(and monitor CD4 count)
Risk of doxycycline (for acne vulgaris)
aplastic anemia
There are 1 in _____ cases of aplastic anemia in patients with chronic viral hepatitis.
30
Causes of spherocytes in the peripheral blood smear include: HS, _____ (4).
- AIHA
- Wilson disease
- Clostridial Septicemia
- Thermal injury
LDH, peripheral blood smear, haptoglobin, serum Hgb, UA, direct coombs test are labs to order if you suspect
AIHA
If a patient with HS is in an aplastic crisis, you would give them ______.
blood transfusion
Treatment for HS includes a splenectomy and ______.
life-long prophylaxis & pneumococcal vaccination
Extrahepatic disorders a/w chronic hepatitis C include, AIHA, ______ (3)
- cryoglobulinemia
- B-cell lymphoma
- ITP
MC Leukopenia
neutropenia
______ is a congenital cause of neutropenia
Kostmann syndrome
MC reason for agranulocytosis is ______.
drug toxicity
Lymphopenia is not usually a loss of lymphocytes, but rather a ______.
change in the distribution of lymphocytes
2 MC causes of lymphopenia
- HIV or viral infection
- malnutrition
(for example, infection = TNF-a will cause T cells to be sequestered to the lymph node)
Deep ulcerations in the mouth, skin infections and colony-like lesions (infection) are signs of _____
leukopenia
Leukopenia tx (2)
- G-CSF (aka Filgrastim)
- broad-spectrum ABX
_____(2) are the largest mediating factors for leukocytosis
- IL-1
- TNF
(both are released in response to infection to stim immune response)
Basophilia (leukocytosis) is commonly seen in _______ disorders
myeloproliferative
______ (leukocytosis) seen in chronic infection, bacterial endocarditis,rickettsiosis, or malaria.
monocytosis
______ (leukocytosis) is seen in viral infections, bordetella pertussus.
Lymphocytosis
(commonly seen w/monocytosis)
Dohle bodies
patches of dilated ER (sky-blue puddles)
(indicates infectious process)
Lymphadentitis
inflammatory process → lymphocytes → secondary lymph tissues → germinal center + T cell zone hyperplasia
Lymphadenopathy present at the lymph nodes are swollen, gray-red and engorged. Histologically, they exhibit prominent ________ and large______.
- neutrophils w/necrosis (“bag of pus”)
- germinal centers




